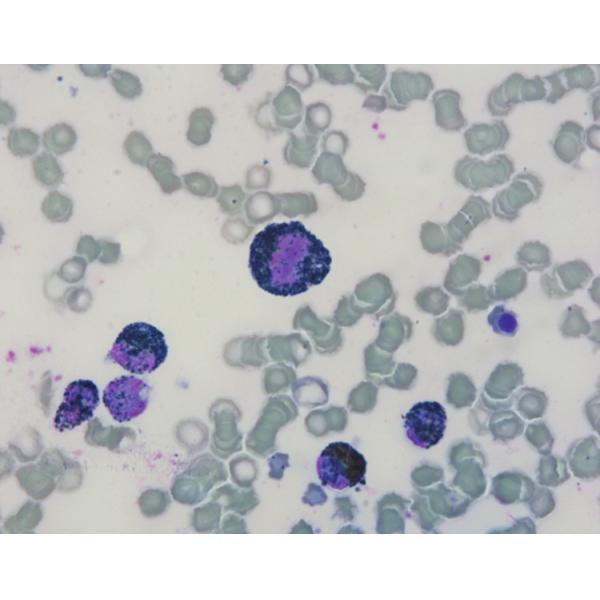

| Sign In | Join Free | My chinacomputerparts.com |
|
| Categories | Cytology Stains |
|---|---|
| Brand Name: | Baso |
| Certification: | IVDR Class A; ISO 13485:2016 |
| Place of Origin: | China |
| Applicable Departments: | Hospital,Clinic,Research Institution |
| Method: | Benzidine |
| MOQ: | 1 Box |
| Price: | Negotiated |
| Payment Terms: | T/T |
| Packaging Details: | Paper box |
| Delivery Time: | To be confirmed |
| Supply Ability: | To be confirmed |
| Company Info. |
| Baso Group |
| Verified Supplier |
| View Contact Details |
| Product List |
Leukocyte Peroxidase Stain (POX) (Benzidine method) Baso Stains
What is Leukocyte Peroxidase Stain (POX) (Benzidine method)?
Intracellular peroxidase catalyzes the transfer of hydrogen atoms from colorless diaminobenzidine (DAB) to hydrogen peroxide, oxidizing DAB into a colored dye that precipitates at the cytoplasmic enzyme sites.
Stain Results
Positive reaction appeared Yellow-brown or Black-blue granules.
Packaging specification
Product Name | Ref # | Specification |
Leukocyte Peroxidase Stain (POX) (Benzidine method) | BA4110A | 5Tests/Kit |
|